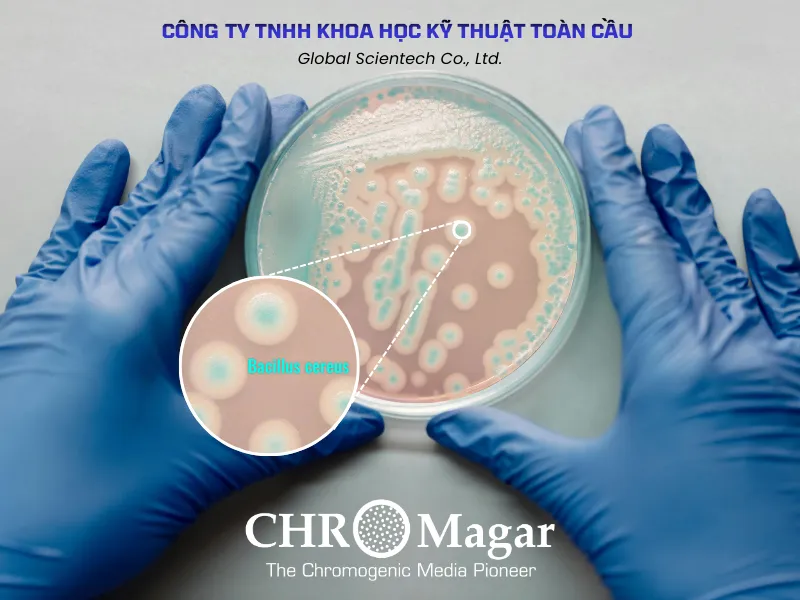
Tối Ưu An Toàn Sinh Học Ngành Sữa: Vai Trò Của CHROMagar B. cereus Trong Nhận Diện Sớm Bacillus cereus

VỀ GLOBAL LAB
Đối Tác Kỹ Thuật Vi Sinh & Sinh Học Phân Tử Hàng Đầu
Với gần 20 năm kinh nghiệm am hiểu thị trường Việt Nam, Global LAB tự hào cung cấp giải pháp toàn diện từ A-Z, cam kết kết nối công nghệ quốc tế đến mọi phòng thí nghiệm.
Chúng tôi không chỉ bán sản phẩm, mà còn cung cấp một hệ sinh thái giải pháp độc đáo:
- Hệ sinh thái trọn gói: Từ vật tư, thiết bị, chủng chuẩn đến chương trình PT phong phú.
- Đối tác toàn cầu: Đại diện cho các thương hiệu hàng đầu như CHROMagar, PCRbio, LGC AXIO...
- Kỹ thuật là sức mạnh: Lấy chuyên môn và sự hỗ trợ tối ưu quy trình làm cam kết cốt lõi.
Được tin dùng bởi các hệ thống kiểm nghiệm uy tín, Global LAB mang lại giá trị thực và độ chính xác cao nhất cho mọi dự án khoa học của bạn.
DANH MỤC NỔI BẬT









TẠI SAO CHỌN CHÚNG TÔI
Globallab cung cấp mọi thứ khách hàng cần tại một nơi, từ hóa chất, thiết bị đến sinh phẩm.
Cam kết tuân thủ các tiêu chuẩn quốc tế, đảm bảo độ tin cậy và hiệu quả.
Được các đơn vị nghiên cứu và xét nghiệm hàng đầu tin tưởng lựa chọn.
Luôn sẵn sàng hỗ trợ khách hàng đạt được mục tiêu khoa học và vận hành.
Đáp ứng mọi nhu cầu chuyên biệt của các phòng thí nghiệm khác nhau.
Sở hữu nền tảng kiến thức và kinh nghiệm vững chắc trong lĩnh vực cung cấp giải pháp cho phòng thí nghiệm.
Tập trung vào việc cung cấp những lợi ích cụ thể và hiệu quả cho khách hàng.
Đảm bảo nguồn cung ứng uy tín và chất lượng sản phẩm.
TIN TỨC MỚI NHẤT
15/04/2026 | 121 Lượt xem
An toàn thực phẩm (ATTP) là thách thức lớn, điển hình qua vụ ngộ độc Salmonella và E. coli tại Đắk Lắk. Phương pháp ISO truyền thống mất 4-6 ngày và thiếu độ chính xác với chủng biến thể (Lac+). Giải pháp Toàn Cầu tích hợp CHROMagar (rút ngắn tăng sinh Salmonella xuống 7 giờ) và Mic Real-time PCR (<25 phút khẳng định gen bằng công nghệ từ tính) giúp giảm TAT xuống 24-48 giờ, đảm bảo phân tích nhanh, chính xác mầm bệnh nguy hiểm.
02/04/2026 | 153 Lượt xem
Trong bối cảnh dịch tả heo Châu Phi (ASFV) tiếp tục gây ra những thách thức lớn cho ngành chăn nuôi, việc thiết lập một quy trình xét nghiệm tại chỗ với độ nhạy cao và tính pháp lý chặt chẽ là ưu tiên hàng đầu của các phòng thí nghiệm (PTN).
Công ty TNHH Khoa học Kỹ thuật Toàn Cầu hân hạnh giới thiệu giải pháp trọn bộ "In-house Real-time PCR", được chuẩn hóa dựa trên các thiết bị và hóa chất hàng đầu thế giới, đáp ứng nghiêm ngặt các tiêu chuẩn kỹ thuật hiện hành.
11/03/2026 | 209 Lượt xem
Môi trường CHROMagar B. cereus được xem như là một giải pháp sàng lọc tiên phong trong quy trình kiểm soát an toàn sinh học cho chuỗi sản xuất sữa trẻ em.
03/03/2026 | 115 Lượt xem
Bạn đã bao giờ tự hỏi làm thế nào chúng ta có thể "nghe" được những lời tự sự thầm kín nhất của sự sống ở cấp độ phân tử? Trong thế giới sinh học hiện đại, Real-Time PCR (qPCR) không chỉ đơn thuần là một kỹ thuật phòng thí nghiệm; nó là chiếc chìa khóa vạn năng giúp chúng ta giải mã các kịch bản di truyền với tốc độ chóng mặt.
25/02/2026 | 209 Lượt xem
Báo cáo nghiên cứu về Acinetobacter baumannii đa kháng thuốc cung cấp cái nhìn chuyên sâu về cơ chế bệnh sinh, thực trạng dịch tễ học toàn cầu và các giải pháp giám sát chủ động bằng công nghệ sinh học tại đơn vị hồi sức tích cực.
10/02/2026 | 138 Lượt xem
Cơ chế Chuyển hóa và Vị trí Tiến hóa Độc đáo của Pyrobaculum aerophilum trong Khử Sắt Dị hóa. Đặc điểm của quá trình khử Fe(III) dị hóa so với khử NO3− ở Cổ khuẩn chịu nhiệt cao Pyrobaculum aerophilum.